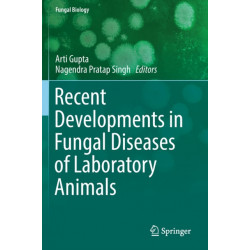
Recent Developments in Fungal Diseases of Laboratory Animals

Ingen varer
Folkeret: økonomi og handel: investeringsaftaler og tvister igen
Der er 16+ underkategorier
- Alternativ medicin for dyr
- Pre-clinical veterinary medicine: basic sciences
- Veterinary medicine: general
- Veterinærmedicin: anatomi og fysiologi
- Veterinærmedicin: eksotiske dyr
- Veterinærmedicin: ernæring
- Veterinærmedicin: farmakologi
- Veterinærmedicin: infektionssygdomme og behandling
- Veterinærmedicin: kirurgi
- Veterinærmedicin: kæledyr
- Veterinærmedicin: laboratoriedyr
- Veterinærmedicin: patologi og histologi
- Veterinærmedicin: produktionsdyr
- Veterinærmedicin: radiologi
- Veterinærmedicin: sygepleje
- Veterinærmedicin: tandbehandling
Veterinærmedicin: laboratoriedyr
Visning: Type : Alle | Sprog : Alle | Format : Alle
-
Bemærk: Kan ikke leveres før jul.
New Advances in SHR Research - Pathophysiology & Pharmacology: Pathophysiology & Pharmacology (Bog, Hardback, Engelsk)This book deals with pathophysiology and pharmacology of spontaneously hypertensive rats (SHR) and describes new trends in SHR research from hemodynamic characteristics to immunological views. It is devoted to the use of tissue culture studies to elaborate SHR characteristics.
Levering: Skaffevare (forvent 14 - 30 hverdage) -
Bemærk: Kan ikke leveres før jul.
The Laboratory Mouse (Bog, Hardback, Engelsk)Revised to reflect advances since the second edition, The Laboratory Mouse continues to be the most accessible reference on the biology and care of the mouse in research settings.
Levering: Skaffevare (forvent 14 - 30 hverdage) -
Bemærk: Kan ikke leveres før jul.
Managing the Laboratory Animal Facility (Bog, Paperback / softback, Engelsk)The thrust of Managing the Laboratory Animal Facilities, beginning with the first edition, has been a focus on basic management skills (planning, directing,... Læs mere
Levering: Skaffevare (forvent 14 - 30 hverdage) -
Bemærk: Kan ikke leveres før jul.
Made to Order: The Designing of Animals (Bog, Hardback, Engelsk)Made to Order explains more than three centuries of attitudes toward animal breeding.
Levering: Skaffevare (forvent 14 - 30 hverdage) -
Bemærk: Kan ikke leveres før jul.
Handbook of Pre-Clinical Continuous Intravenous Infusion (Bog, Hardback, Engelsk)The Handbook of Pre-clinical Continuous Intravenous Infusion answers the needs of researchers and technicians involved with pharmacological testing by providing complete instructions in a single volume reference for a range of infusion techniques delivered to several species.
Levering: Skaffevare (forvent 14 - 30 hverdage) -
Bemærk: Kan ikke leveres før jul.
Handbook of Mouse Mutations with Skin and Hair Abnormalities: Animal Models and Biomedical Tools (Bog, Hardback, Engelsk)Handbook of Mouse Mutations with Skin and Hair Abnormalities presents 48 mouse mutations that are all available to the biomedical community
Levering: Skaffevare (forvent 14 - 30 hverdage) -
Bemærk: Kan leveres før jul.
Trace Elements in Laboratory Rodents (Bog, Hardback, Engelsk)Written by the international community's leading experts, Trace Elements in Laboratory Rodents describes the best and most current methods to provide deficient or supplemental trace elements to laboratory animals, as well as how to assay them
Levering: 6 - 9 hverdage -
Bemærk: Kan ikke leveres før jul.
Recent Developments in Fungal Diseases of Laboratory Animals (Bog, Paperback / softback, Engelsk)Fungal growths affect both human and animal well-being. This book provides a valuable source of information to biologicaland biomedical scientists and to clinical and doctoral researchers working in the area of fungal infections and diseases of laboratory animal species.
Levering: Skaffevare (forvent 14 - 30 hverdage) -
Bemærk: Kan leveres før jul.
Critical Care Management for Laboratory Mice and Rats (Bog, Paperback / softback, Engelsk)Levering: 6 - 9 hverdage -
Bemærk: Kan leveres før jul.
Asking Animals: An Introduction to Animal Behaviour Testing (Bog, Paperback / softback, Engelsk)This book gives an introduction to the use of behaviour tests applied to animals. By including illustrative examples from a variety of species,... Læs mere
Levering: 6 - 9 hverdage -
Bemærk: Kan ikke leveres før jul.
Health and Safety in Laboratory Animal Facilities (Bog, Paperback / softback, Engelsk)This text provides guidance on assessing hazards and risks in the animal laboratory and how to eliminate or minimize them. It also emphasizes that each facility is unique and must be assessed locally by persons familiar with each aspect.
Levering: Skaffevare (forvent 14 - 30 hverdage) -
Bemærk: Kan ikke leveres før jul.
Managing the Laboratory Animal Facility (Bog, Hardback, Engelsk)Levering: Skaffevare (forvent 14 - 30 hverdage)